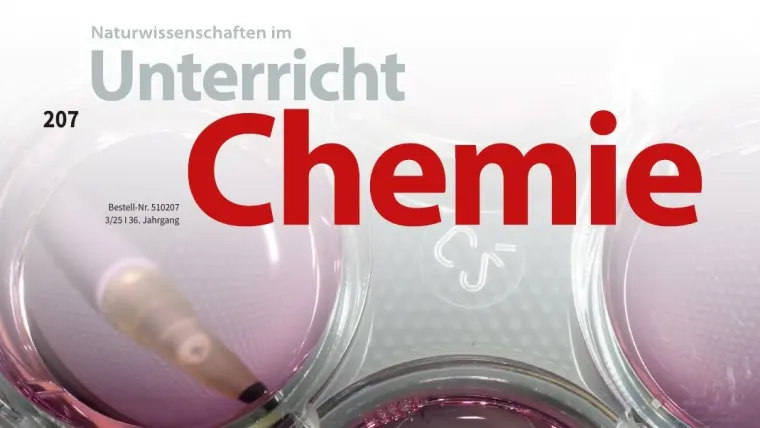
Cover of the magazine: Unterricht Chemie

The specialist magazine Unterricht Chemie introduces SFB 1278 "PolyTarget" research to schools, showcasing nanomedicine in an engaging, classroom-friendly format.
Cover of the magazine: Unterricht Chemie
Published:
Contents page of the Teaching Chemistry Magazine
Illustration: Unterricht ChemieThe latest issue of the educational magazine Unterricht Chemie – Specialist Magazine presents the research of the Collaborative Research Center 1278 "PolyTarget" of the German Research Foundation at Friedrich Schiller University Jena and its partners. It highlights innovative approaches in polymer-based nanomedicine, presented in a clear and practical format for classroom use.
Through ready-to-use teaching materials and accessible insights, the magazine aims to inspire students and connect school chemistry with real-world science.
The issue can be found here: Unterricht Chemie – Specialist MagazineExternal link
Promotional video of SFB 1278 Polytarget project
Screenshot: Sonderforschungsbereich 1278 PolyTarget
